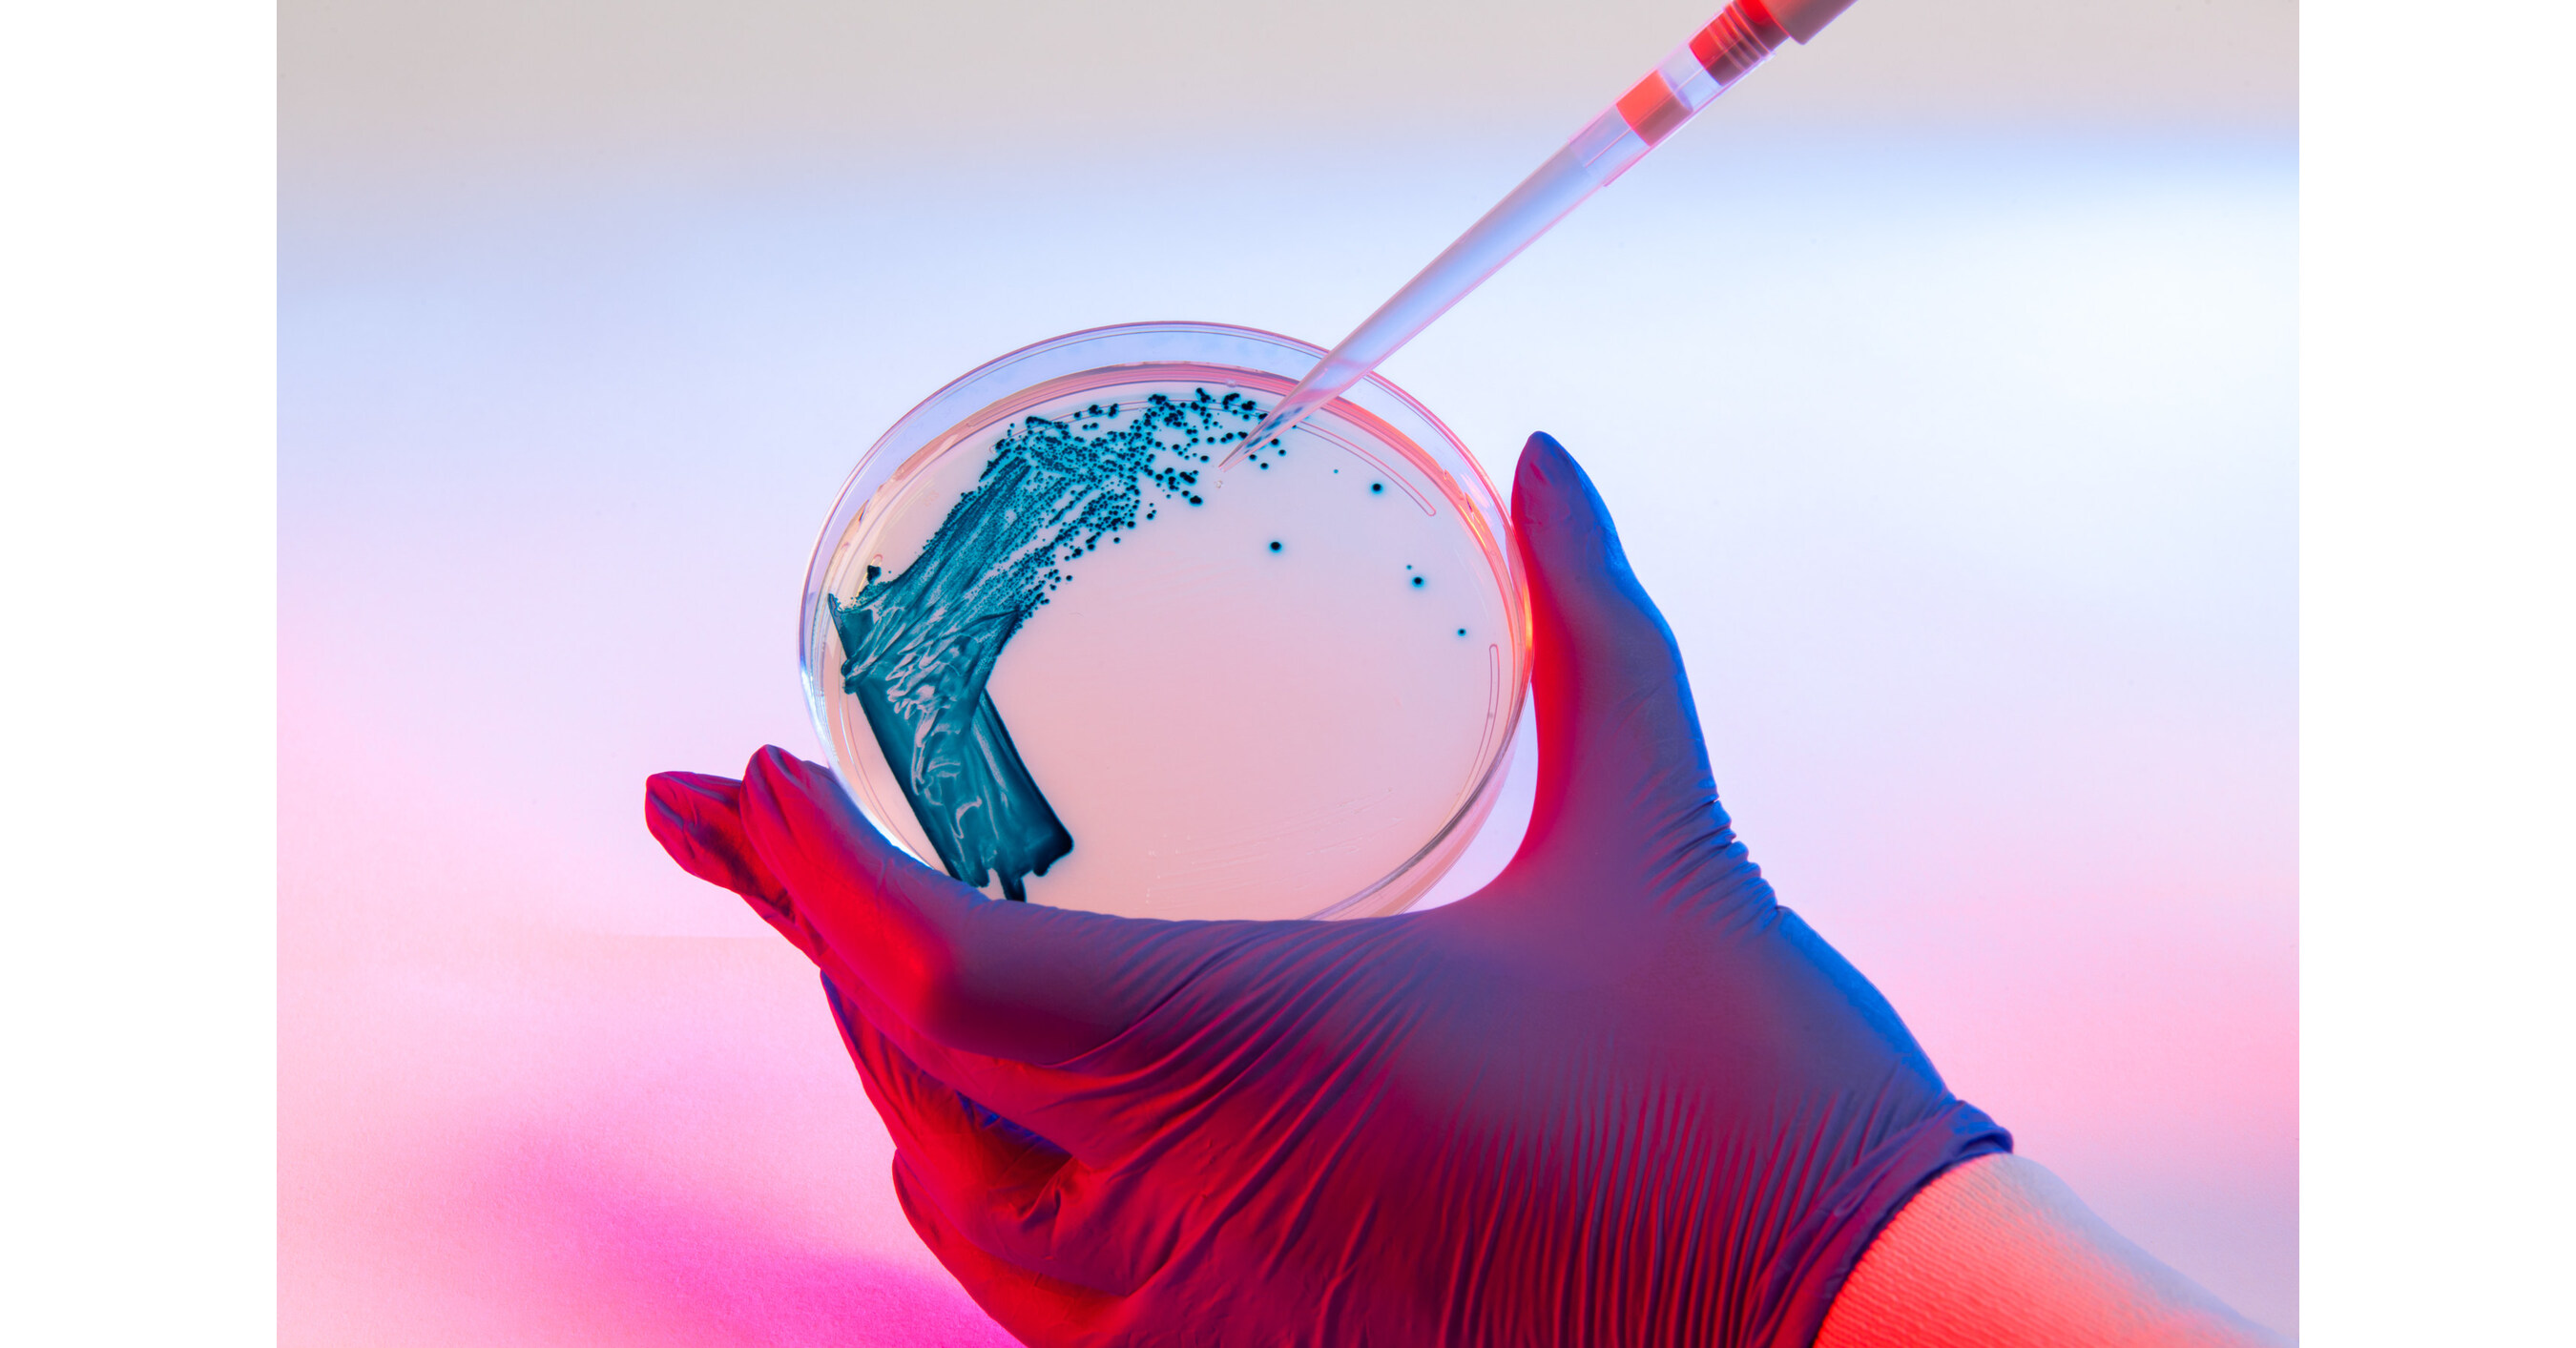

Marketing Assistant, The Rinks
Irvine, CA (On-site)
Posted 3 days ago
Before you apply
Give them a reason to pay attention.
Job Summary
Original Job Description
We Engineer Solutions for the Nation’s Toughest ProblemsAs an independent nonprofit engineering innovation company, Draper provides engineering services directly to government, industry, and academia. We work on teams as prime contractors or subcontractors and participate as collaborators in consortia.Our strong commitment to delivering working solutions allows us to apply ourselves to a variety of domains from space to undersea — and many areas in between.
Unlock full insights for this role
See the hiring team, company signals, and the context that helps you decide whether this role is worth your time.
Create an account to see the full company intelligence for this role.
Traffic Signals
Headcount Trend
Marketing Team
People
Hiring Team


6 contacts found
Reach the hiring team directly
Skip the queue — see recruiters, HR, and marketing leaders for this role.
Funding
Funding History
- Feb 2026Grant • $26.7M
- Nov 2024Grant • $3.0M
- Nov 2023Grant • $26.0M
Recent News
AI Career Coach
Career Coach can make mistakes. Consider verifying important information.